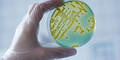
Bakterien

EU-Projekt mit Grazer Beteiligung will unnötige Antibiotikagaben reduzieren
Wenn Kinder Fieber bekommen, ist oft nicht klar, ob es sich um einen harmlosen Infekt, oder eine gefährliche Infektion handelt. Wenig erfahrene Eltern sind schnell beunruhigt. Europaweit bemühen sich Forscher, durch bessere medizinische Diagnose von fiebernden Kindern den Antibiotikaeinsatz wie auch die Klinikaufenthalte zu reduzieren. Federführend mit dabei sind Forscher aus Graz.
Ab wann spricht man von Fieber?
Steigt die Körpertemperatur über 38,0 Grad Celsius - im After gemessen - spricht man von Fieber. Meist ist der Körper dann mit der Abwehr von "alltäglichen" Virusinfektionen wie Erkältungen und Grippe, Magen-Darm-Infekten oder einer Entzündung beschäftigt, schilderte Werner Zenz von der Klinischen Abteilung für Allgemeine Pädiatrie der Med-Uni Graz im APA-Gespräch. Es kann aber auch von gefährlichen Infekten wie Lungenentzündung oder einer Hirnhautentzündung (Meningitis) herrühren, die gravierende Komplikationen mit sich ziehen oder tödlich enden können.
Ernstfall ist schwer von harmloser Erkrankung zu unterscheiden
Daher herrscht immer wieder Verunsicherung: Manche Eltern geben fiebersenkende Mittel, obwohl die Temperatur kaum erhöht ist - und bekämpfen damit noch dazu das Symptom und nicht die Ursache. Andere bringen ihr überhitztes Kind ins Krankenhaus, statt ihm Ruhe zu gönnen, einige kommen wiederum zu spät ins Spital. Vor allem zu Beginn sei die Unterscheidung zwischen harmlosen Viruserkrankungen und beispielsweise einer gefährlichen, wenn auch seltenen, bakteriellen Infektion jedoch nur schwer zu treffen: "Ein bis dato völlig gesundes Kind kann innerhalb weniger Stunden an einer Meningokokkeninfektion versterben", gab Zenz im Gespräch mit der APA ein Beispiel für die möglichen Auswirkungen einer seltenen, aber sehr gefährlichen bakteriellen Infektionserkrankung.
Unnötige antibiotische Therapien sind keine Seltenheit
"Wir wollen keinen Fehler machen und nehmen dafür invasive Untersuchungen, oftmals unnötige antibiotische Therapien in Kauf", schilderte Zenz das Dilemma, vor dem daher Ärzte bei der Behandlung des oftmals nicht klar zuordenbaren Fiebers stehen. "Neben der möglicherweise vermeidbaren Belastung für die Kinder entstehen als Folge dieser Vorgangsweise jedoch auch antibiotische Resistenzen sowie enorme Kosten für das Gesundheitssystem", gab er zu bedenken.
Neue Labortests sollen Diagnose erleichtern
Seit mehreren Jahren bauen Kinderärzte, Infektiologen, Molekularbiologen und Genetiker daher ein europäisches Forschungsnetzwerk auf, das eine verbesserte Diagnostik und Therapie von fiebernden Kindern zum Ziel hat. Die Gruppe hat nun ein Projekt im Umfang von 18 Mio. Euro an Land gezogen, das europaweite Standards für deren medizinische Diagnose und Betreuung schaffen will.
So will man neue und einfachere Labortests entwickeln, die schneller zwischen bakteriellen und viralen Infektionen unterscheiden können, wie Zenz schilderte. Er stellt an der Med-Uni Graz das österreichische Team im EU-Projekt, das auf vier Jahre anberaumt ist. In Graz beschäftigen sich die Wissenschafter um Zenz schon seit Jahren mit der Erforschung des genetischen Hintergrundes von Infektionserkrankungen. Sie wollen im Rahmen des Projektes unter anderem einen Marker für die Infektion von Bakterien, die Gesichtslähmung (Facialisparese) hervorrufen, finden.
Weniger stationäre Aufnahmen und Antibiotika
Gemeinsames Ziel werde es sein, das derzeitige Vorgehen bei der Betreuung fiebernder Kinder in verschiedenen europäischen Gesundheitssystemen zu erheben und europaweite Standards zum Management zu etablieren: "Stationäre Aufnahmen, invasive Untersuchungsmethoden sowie der Einsatz von Antibiotika sollen langfristig gekürzt werden", blickt Zenz in die Zukunft.
Lieber auf das Befinden des Kindes, als auf die Temperatur achten
Eltern von fiebernden Kindern rät Zenz bis dahin, nicht nur auf das Thermometer, sondern auf das allgemeine Befinden des Kindes zu achten: Wenn das Fieber mehrere Tage ohne erkennbare Ursache andauert bzw. mit Atemnot, Erbrechen, Durchfall oder Nackensteifigkeit einhergeht, sollte der Arzt aufgesucht werden, ebenso bei Säuglingen unter drei Monaten. "Eltern haben an und für sich ein gutes Gespür, es geht auch darum den Hausverstand und nicht die Panik walten zu lassen."